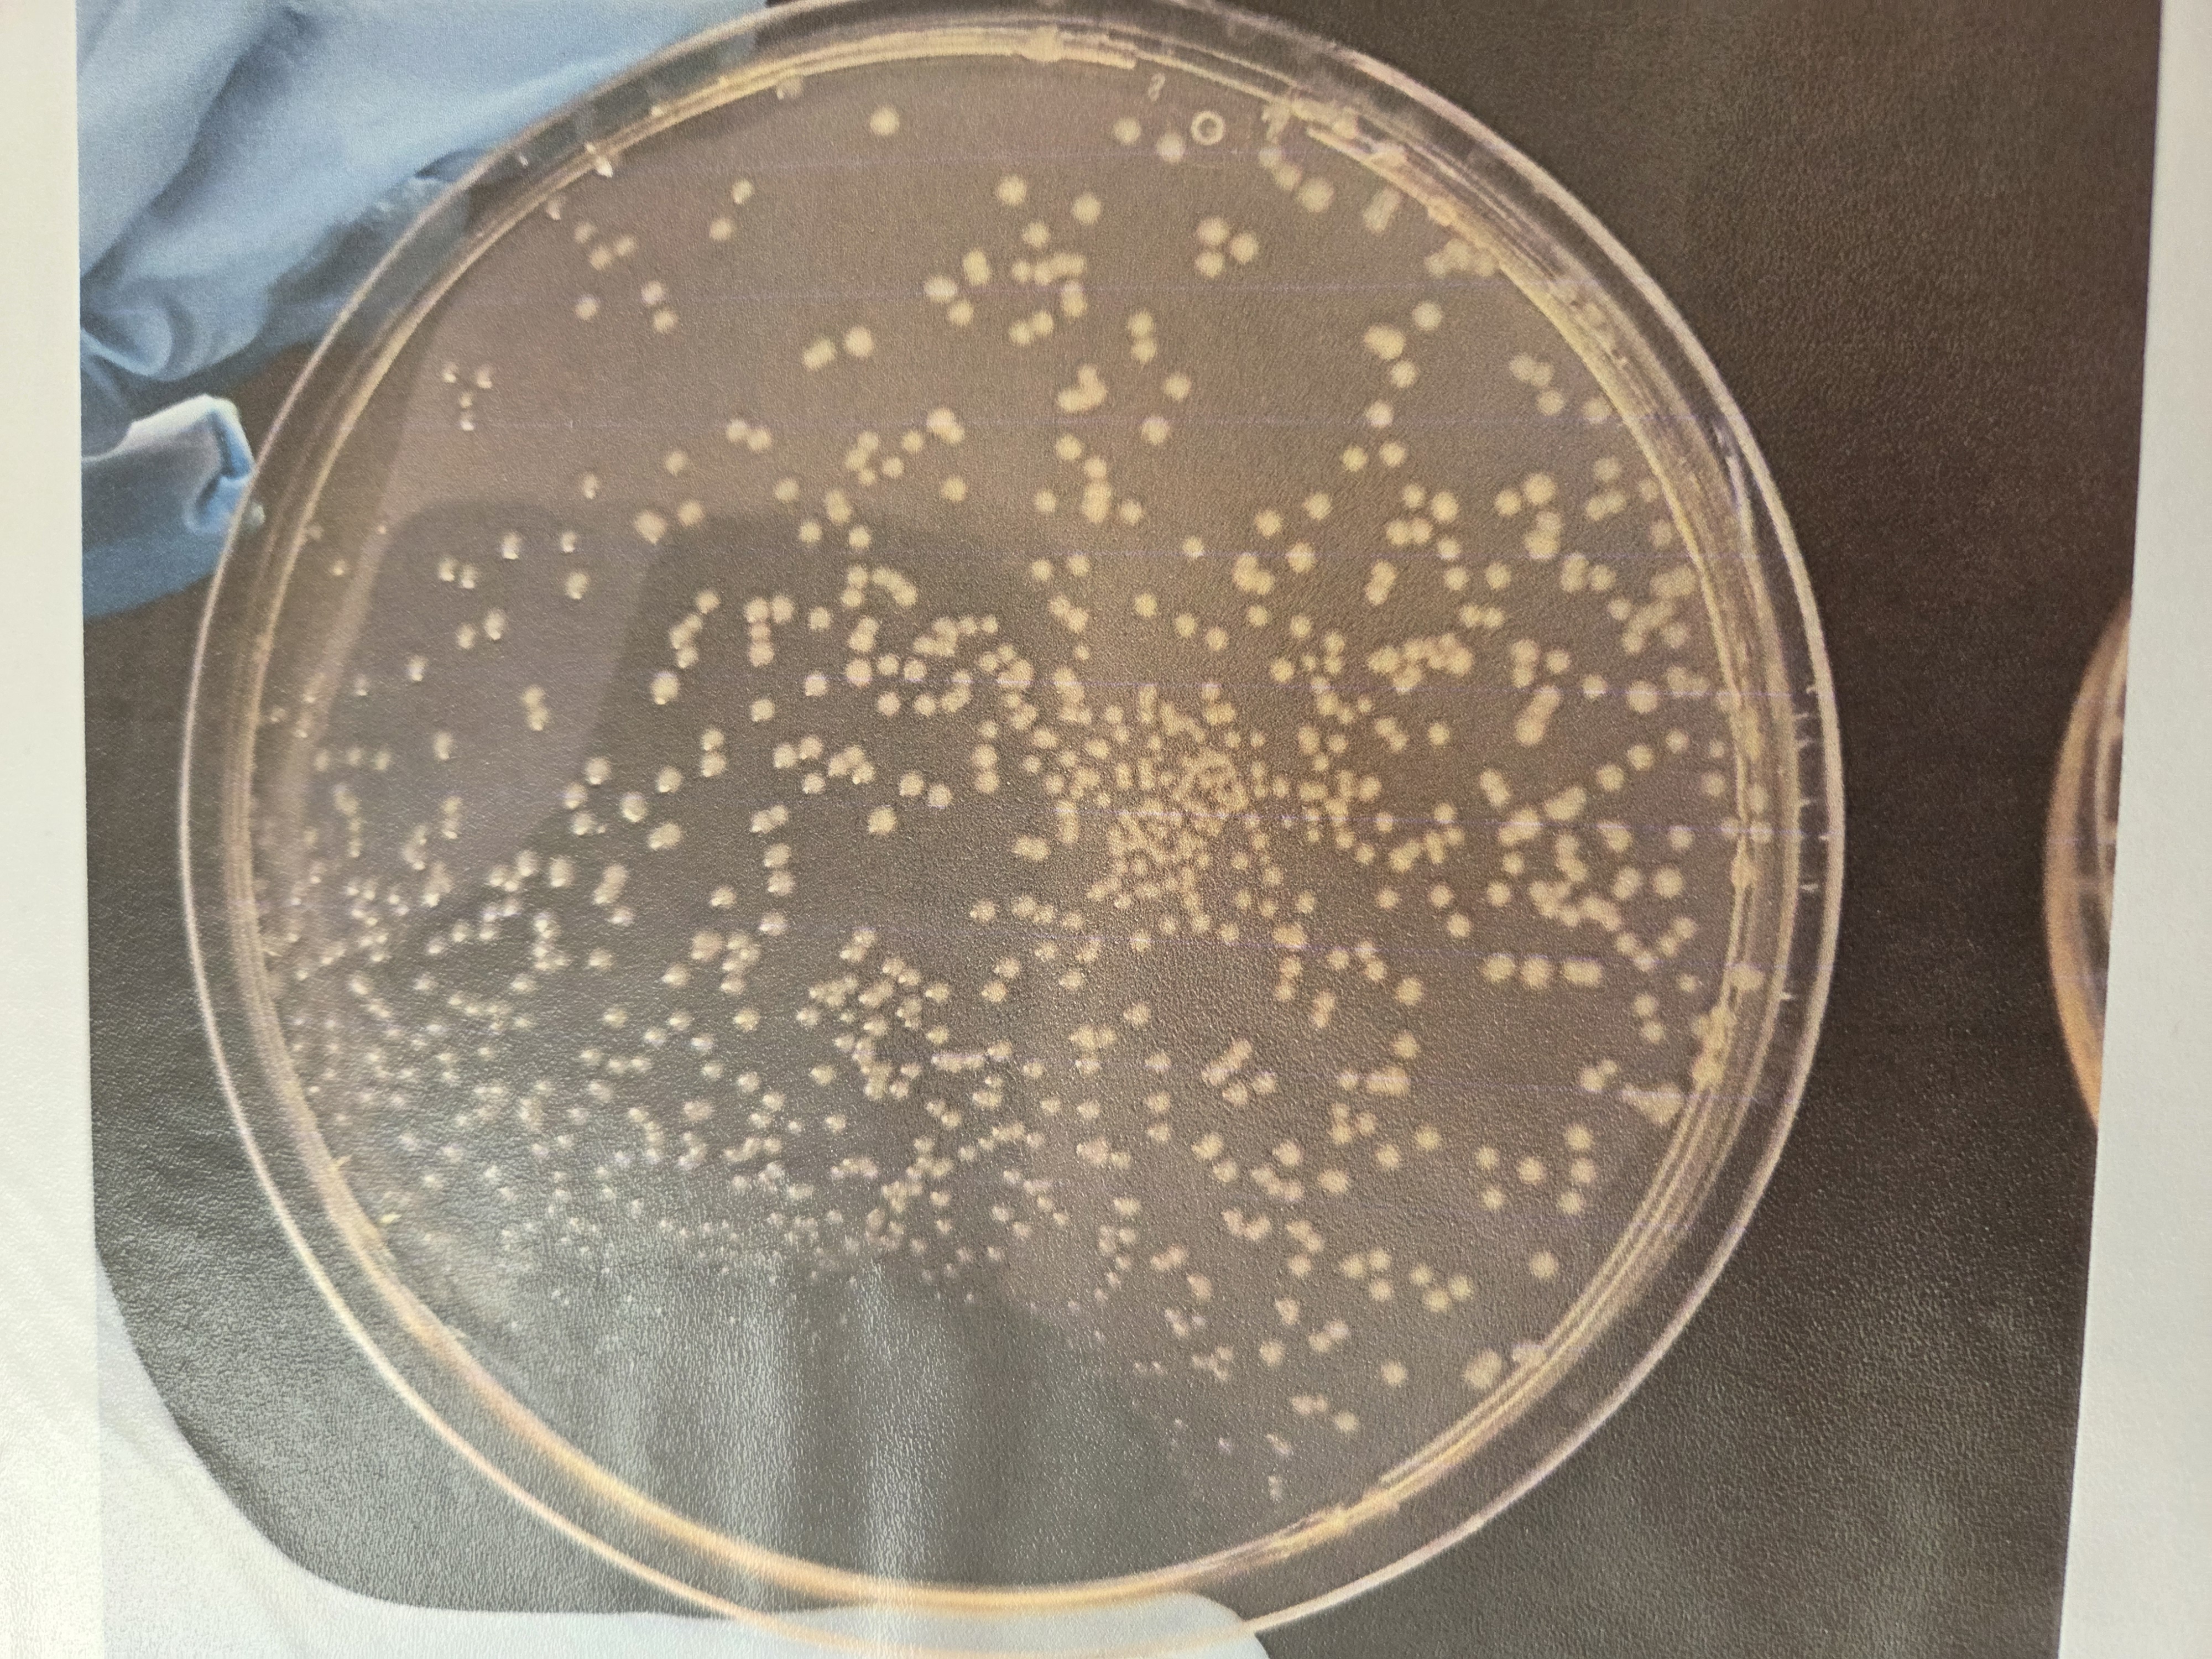
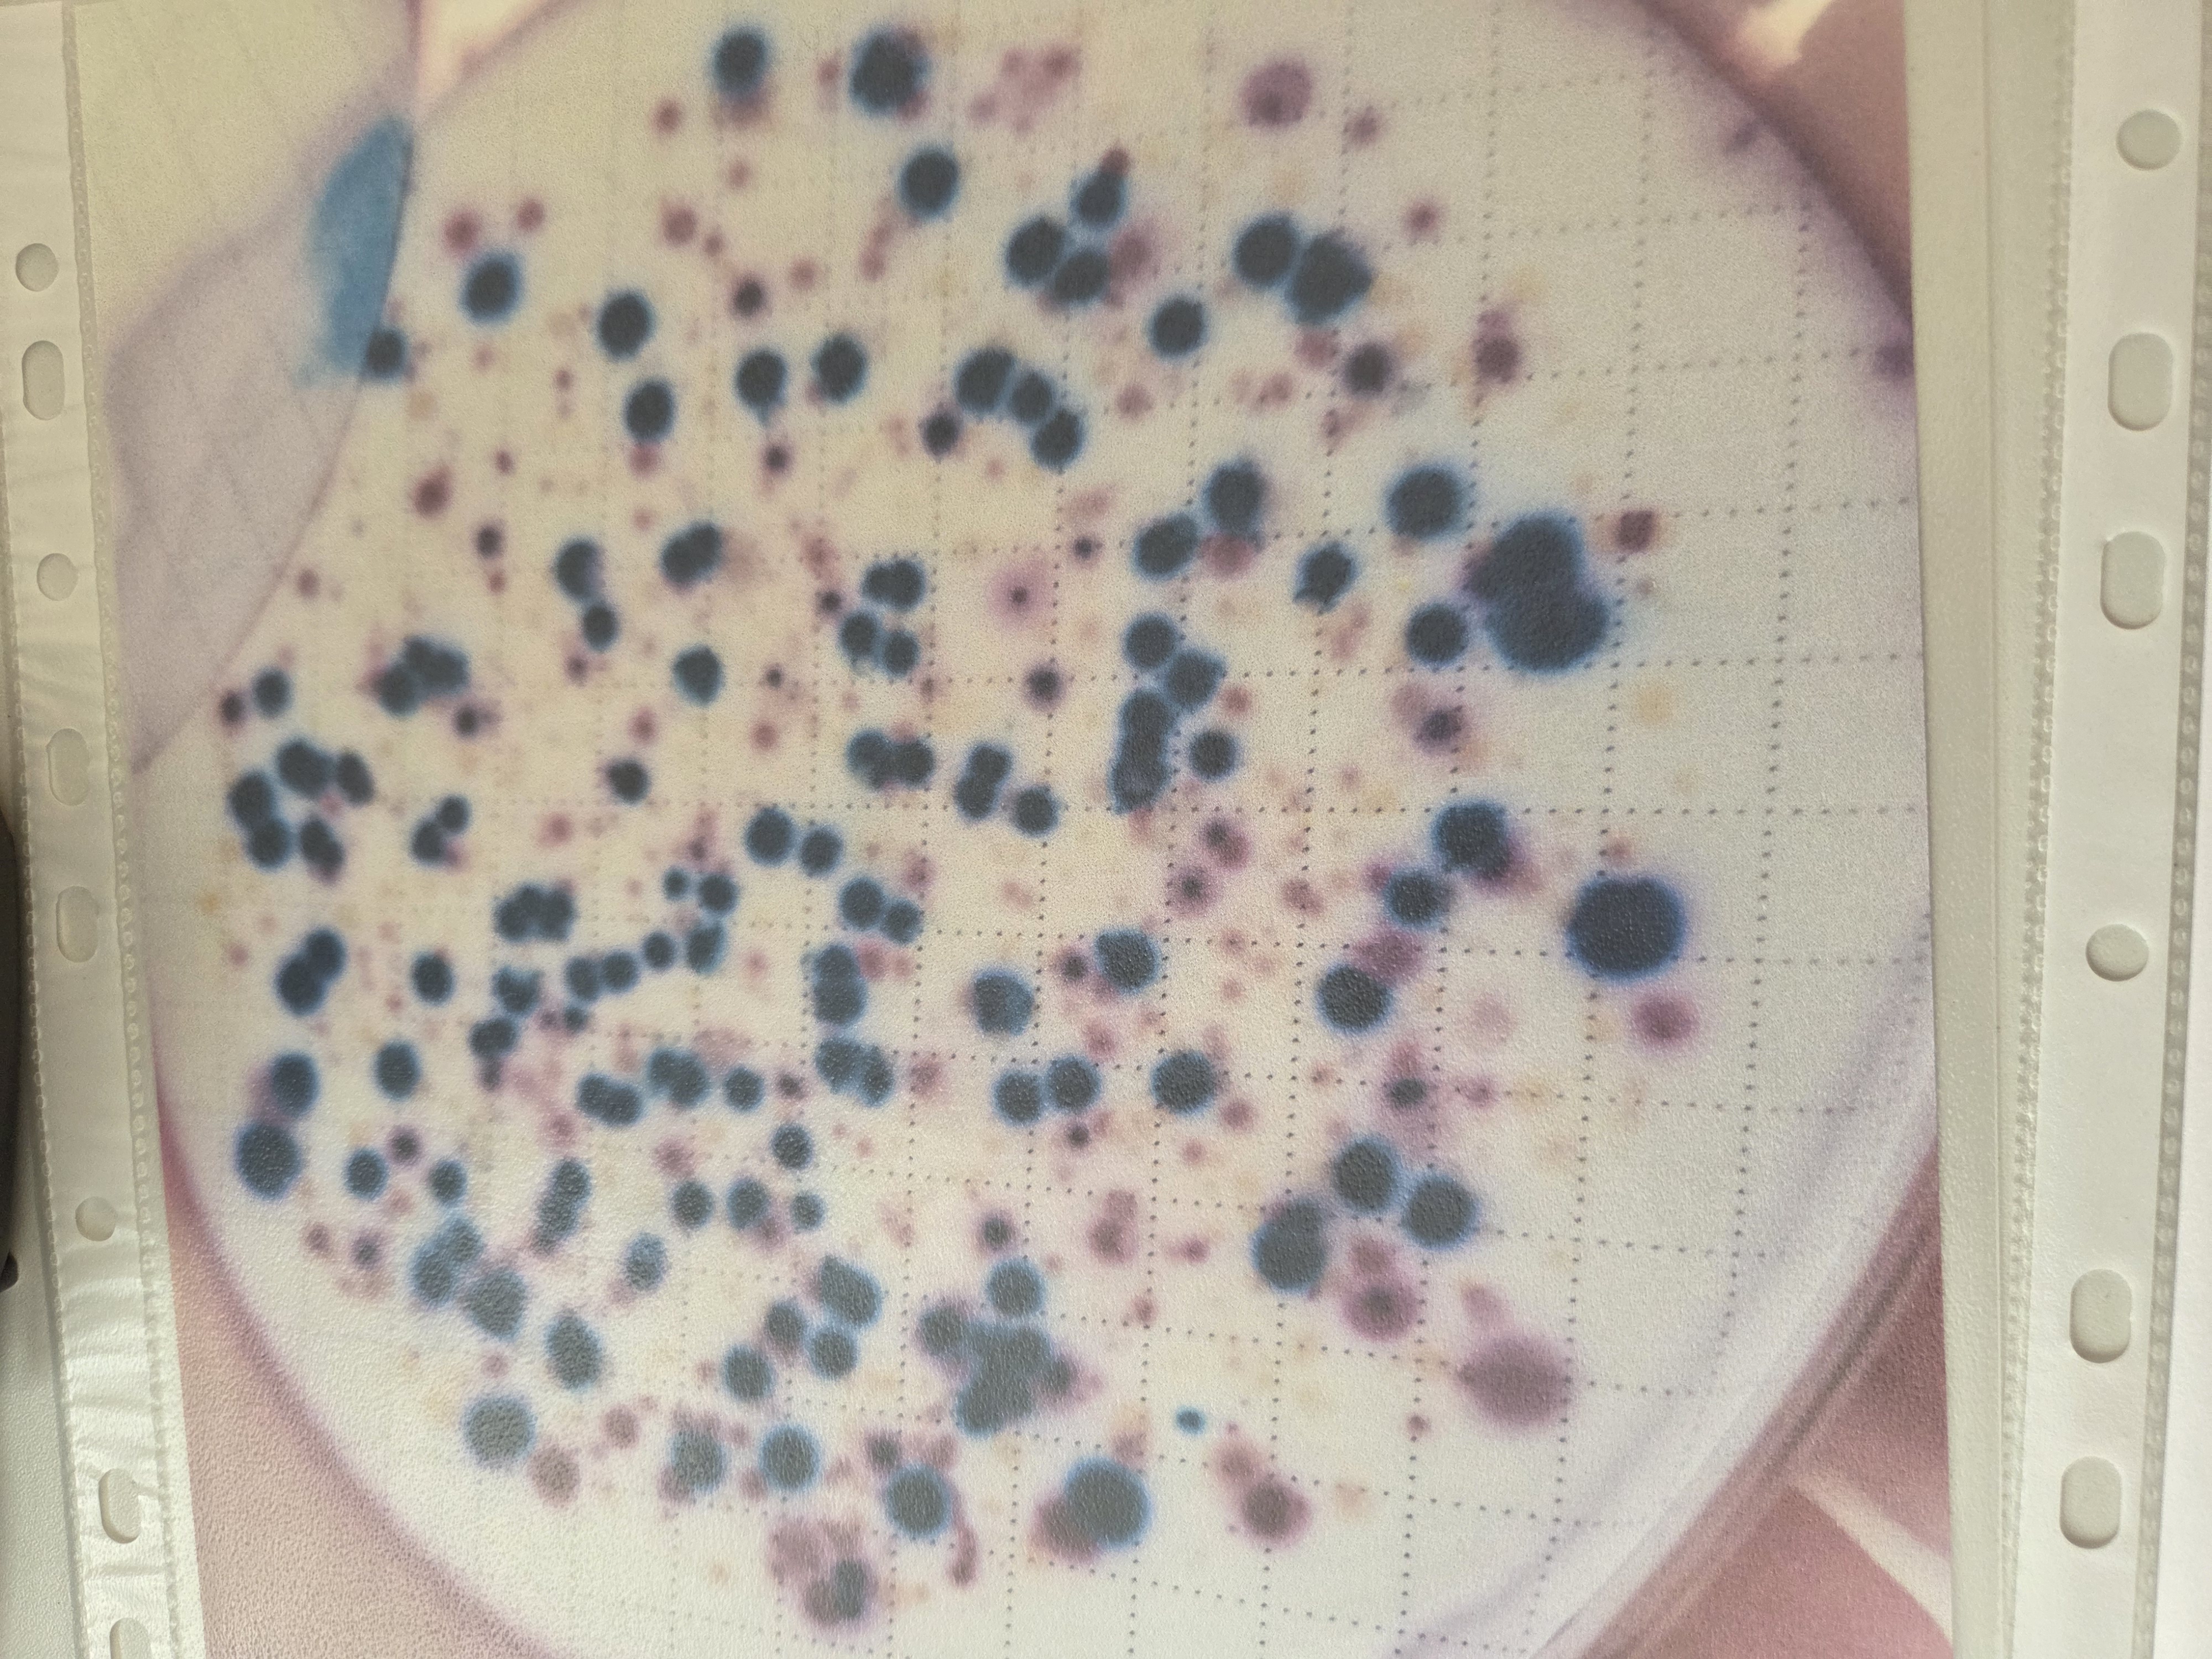

DNI OTWARTE PSSE W CIECHANOWIE 9-10 KWIETNIA 2026 r.

Za nami DNI OTWARTE – i co to były za dni! ✨🔬
9-10 kwietnia 2026 r. ponownie szeroko otworzyliśmy drzwi naszej stacji, aby zapoznać odwiedzających z naszą codzienną pracą, przybliżyć naszą misję i zdradzić „tajniki” badań prowadzonych w laboratoriach.
Pierwszego dnia mieliśmy przyjemność gościć pracowników oświaty, seniorów oraz przedstawicieli podmiotów leczniczych. Wydarzenie otworzyliśmy cyklem prelekcyjnym, który miał na celu pokazać jak działamy na co dzień na rzecz zdrowia publicznego. To był doskonały czas na zadawanie pytań, rozwianie wątpliwości, konsultacje.
Cykl prelekcyjny obejmował tematy:
Zdrowie zaczyna się od profilaktyki
Bezpieczny plac zabaw
HPV- program bezpłatnych szczepień dla dzieci
Świadomy wybór – jak analizować etykiety produktów kosmetycznych?
Poidełka w placówkach oświatowych – bezpieczeństwo zdrowotne wody
Zasady żywienia w placówkach oświatowo – wychowawczych
„Lepiej zapobiegać niż leczyć” – profilaktyka w praktyce.
Kolejnego dnia nasze laboratoria tętniły życiem – było kolorowo, magicznie
i niezwykle inspirująco! Najmłodsi z ogromnym zaciekawieniem odkrywali świat nauki poprzez atrakcyjne zajęcia i doświadczenia, które na długo zostaną w ich pamięci.
Pod mikroskopem obserwowaliśmy drożdże, wyhodowaną pleśń, lampy lawy, bakterie wyhodowane z rozmaitych powierzchni: klamek, poręczy, telefonów komórkowych itp. – co wzbudziło niemałe emocje! 🦠😄 Było też ważenie, eksperymenty z napięciem powierzchniowym z użyciem brokatu oraz barwienie przy pomocy naturalnych składników – kapusty, szpinaku i kwasku cytrynowego. Ogromnym zainteresowaniem cieszyła się również ekspozycja sprzętu laboratoryjnego – można było zobaczyć
z bliska jak wygląda nasza codzienna praca „od kuchni”. Nasi Goście mogli również sprawdzić czy dokładnie myją swoje ręce przy pomocy specjalnej lampy UV. Frekwencja przerosła nasze oczekiwania – było tłoczno, gwarno i bardzo energetycznie! Co więcej, mamy już pierwsze deklaracje od najmłodszych, że
w przyszłości chcą pracować w PSSE – i to jest dla nas największa satysfakcja 💚
Dziękujemy za obecność i wspólnie spędzony czas! Do zobaczenia przy kolejnych okazjach 👋!
Zdjęcia (67)
 Pokaż zdjęcie 2 z galerii.
Pokaż zdjęcie 2 z galerii.
 Pokaż zdjęcie 3 z galerii.
Pokaż zdjęcie 3 z galerii.
 Pokaż zdjęcie 4 z galerii.
Pokaż zdjęcie 4 z galerii.
 Pokaż zdjęcie 5 z galerii.
Pokaż zdjęcie 5 z galerii.
 Pokaż zdjęcie 6 z galerii.
Pokaż zdjęcie 6 z galerii.
 Pokaż zdjęcie 7 z galerii.
Pokaż zdjęcie 7 z galerii.
Pokaż zdjęcie 8 z galerii.
Pokaż zdjęcie 8 z galerii.
Pokaż zdjęcie 9 z galerii.
Pokaż zdjęcie 9 z galerii.
 Pokaż zdjęcie 10 z galerii.
Pokaż zdjęcie 10 z galerii.
 Pokaż zdjęcie 11 z galerii.
Pokaż zdjęcie 11 z galerii.
 Pokaż zdjęcie 12 z galerii.
Pokaż zdjęcie 12 z galerii.
 Pokaż zdjęcie 13 z galerii.
Pokaż zdjęcie 13 z galerii.
 Pokaż zdjęcie 14 z galerii.
Pokaż zdjęcie 14 z galerii.
 Pokaż zdjęcie 15 z galerii.
Pokaż zdjęcie 15 z galerii.
 Pokaż zdjęcie 16 z galerii.
Pokaż zdjęcie 16 z galerii.
 Pokaż zdjęcie 17 z galerii.
Pokaż zdjęcie 17 z galerii.
 Pokaż zdjęcie 18 z galerii.
Pokaż zdjęcie 18 z galerii.
 Pokaż zdjęcie 19 z galerii.
Pokaż zdjęcie 19 z galerii.
 Pokaż zdjęcie 20 z galerii.
Pokaż zdjęcie 20 z galerii.
 Pokaż zdjęcie 21 z galerii.
Pokaż zdjęcie 21 z galerii.
 Pokaż zdjęcie 22 z galerii.
Pokaż zdjęcie 22 z galerii.
 Pokaż zdjęcie 23 z galerii.
Pokaż zdjęcie 23 z galerii.
 Pokaż zdjęcie 24 z galerii.
Pokaż zdjęcie 24 z galerii.
 Pokaż zdjęcie 25 z galerii.
Pokaż zdjęcie 25 z galerii.
 Pokaż zdjęcie 26 z galerii.
Pokaż zdjęcie 26 z galerii.
 Pokaż zdjęcie 27 z galerii.
Pokaż zdjęcie 27 z galerii.
 Pokaż zdjęcie 28 z galerii.
Pokaż zdjęcie 28 z galerii.
 Pokaż zdjęcie 29 z galerii.
Pokaż zdjęcie 29 z galerii.
 Pokaż zdjęcie 30 z galerii.
Pokaż zdjęcie 30 z galerii.
 Pokaż zdjęcie 31 z galerii.
Pokaż zdjęcie 31 z galerii.
 Pokaż zdjęcie 32 z galerii.
Pokaż zdjęcie 32 z galerii.
 Pokaż zdjęcie 33 z galerii.
Pokaż zdjęcie 33 z galerii.
 Pokaż zdjęcie 34 z galerii.
Pokaż zdjęcie 34 z galerii.
 Pokaż zdjęcie 35 z galerii.
Pokaż zdjęcie 35 z galerii.
 Pokaż zdjęcie 36 z galerii.
Pokaż zdjęcie 36 z galerii.
 Pokaż zdjęcie 37 z galerii.
Pokaż zdjęcie 37 z galerii.
 Pokaż zdjęcie 38 z galerii.
Pokaż zdjęcie 38 z galerii.
 Pokaż zdjęcie 39 z galerii.
Pokaż zdjęcie 39 z galerii.
 Pokaż zdjęcie 40 z galerii.
Pokaż zdjęcie 40 z galerii.
 Pokaż zdjęcie 41 z galerii.
Pokaż zdjęcie 41 z galerii.
 Pokaż zdjęcie 42 z galerii.
Pokaż zdjęcie 42 z galerii.
 Pokaż zdjęcie 43 z galerii.
Pokaż zdjęcie 43 z galerii.
 Pokaż zdjęcie 44 z galerii.
Pokaż zdjęcie 44 z galerii.
 Pokaż zdjęcie 45 z galerii.
Pokaż zdjęcie 45 z galerii.
 Pokaż zdjęcie 46 z galerii.
Pokaż zdjęcie 46 z galerii.
 Pokaż zdjęcie 47 z galerii.
Pokaż zdjęcie 47 z galerii.
 Pokaż zdjęcie 48 z galerii.
Pokaż zdjęcie 48 z galerii.
 Pokaż zdjęcie 49 z galerii.
Pokaż zdjęcie 49 z galerii.
 Pokaż zdjęcie 50 z galerii.
Pokaż zdjęcie 50 z galerii.
 Pokaż zdjęcie 51 z galerii.
Pokaż zdjęcie 51 z galerii.
 Pokaż zdjęcie 52 z galerii.
Pokaż zdjęcie 52 z galerii.
 Pokaż zdjęcie 53 z galerii.
Pokaż zdjęcie 53 z galerii.
 Pokaż zdjęcie 54 z galerii.
Pokaż zdjęcie 54 z galerii.
 Pokaż zdjęcie 55 z galerii.
Pokaż zdjęcie 55 z galerii.
 Pokaż zdjęcie 56 z galerii.
Pokaż zdjęcie 56 z galerii.
 Pokaż zdjęcie 57 z galerii.
Pokaż zdjęcie 57 z galerii.
 Pokaż zdjęcie 58 z galerii.
Pokaż zdjęcie 58 z galerii.
 Pokaż zdjęcie 59 z galerii.
Pokaż zdjęcie 59 z galerii.
 Pokaż zdjęcie 60 z galerii.
Pokaż zdjęcie 60 z galerii.
 Pokaż zdjęcie 61 z galerii.
Pokaż zdjęcie 61 z galerii.
 Pokaż zdjęcie 62 z galerii.
Pokaż zdjęcie 62 z galerii.
 Pokaż zdjęcie 63 z galerii.
Pokaż zdjęcie 63 z galerii.
 Pokaż zdjęcie 64 z galerii.
Pokaż zdjęcie 64 z galerii.
 Pokaż zdjęcie 65 z galerii.
Pokaż zdjęcie 65 z galerii.
 Pokaż zdjęcie 66 z galerii.
Pokaż zdjęcie 66 z galerii.
 Pokaż zdjęcie 67 z galerii.
Pokaż zdjęcie 67 z galerii.
